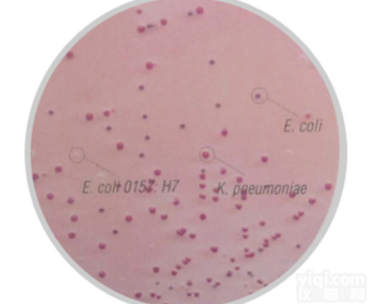
M1340  <em>大肠杆菌O157：H7显色培养基</em>
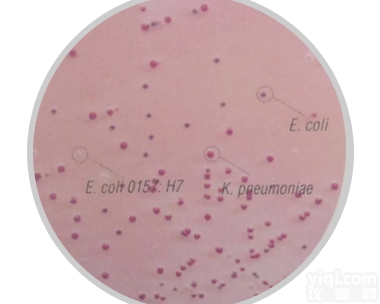
M1340  <em>大肠杆菌O157：H7显色培养基</em>

大肠杆菌O157:H7显色培养基
- 品牌:HiMedia
- 型号:M1340
- 供应商:北京缔一生物科技有限公司
- 供应商报价:询价
- 标签:大肠杆菌O157:H7显色培养基、大肠杆菌O157:H7显色培养基价格、大肠杆菌O157:H7显色培养基厂家、、、北京缔一生物科技有限公司
大肠杆菌O157:H7显色培养基
HiCrome MacConkey Sorbitol Agar Base
| 货号 | 品名 | 规格 | 储存条件 | 保质期 |
| M1340 | HiCrome™ MacConkey Sorbitol Agar Base | 100g(2L) 500g(10L) | 2-8℃ | 详见包装品 |
| FD147-5VL | Tellurite - Cefixime Supplement | 5管(2.5L) | 详见包装品 |
原理
麦康凯山梨醇琼脂培养基 是根据Rappaport和Henigh的文献描述而制备的(1)。培养基中含有山梨醇和BC指示剂,不含乳糖。用于鉴别大肠杆菌O157:H7肠道病原菌。
大多数大肠菌群菌株 会发酵山梨醇,产生酸。当pH值低于6.8时,培养基中的中性红会变成粉红色。同时普通大肠杆菌具有ß-D葡萄糖醛酸酶,当遇到培养基中BC指示剂时,会呈现蓝绿色。当两种颜色叠加时,普通大肠杆菌在此种培养基中,会呈现蓝紫色。
大肠杆菌O157:H7不发酵山梨醇(2),也不具备ß-D葡萄糖醛酸酶活性(3),因而在此种培养基中产生的菌落为无色。
March和Ratnam报告(2),山梨醇麦康凯琼脂培养基对大肠杆菌O157:H7的检测具有的敏感性和85%的特异性,该培养基可作为筛选大肠杆菌O157:H7的可靠手段。
此培养基中:碳源、氮源及其它必要的生长营养素,由酪蛋白酶解产物和䏡蛋白胨提供;结晶紫和胆盐会YZ大多数革兰氏阳性菌生长;培养基中的氯化钠维持渗透压平衡。
如果需要,此培养基还可添加 碲酸盐头孢克肟添加剂(FD147),可使培养基更具有选择性(4)。亚碲酸钾可使大肠杆菌O157选择性生长,并YZ嗜水气单胞菌和普罗维登菌的生长;头孢克肟可YZ变形杆菌。
注:假单胞菌在此培养基中也可产生无色菌落。若需对可疑菌落辨别,可进行氧化酶试验,在5-10秒内观察结果。
应用
HiCrome™麦康凯山梨醇琼脂培养基 推荐用于从食物和动物饲料中选择性分离大肠杆菌O157:H7。
培养基成分
成分 克/升
酪蛋白酶水解物 17
䏡蛋白胨 3
山梨醇 10
胆盐混合物 1.5
氯化钠 5
结晶紫 0.01
中性红 0.03
BC指示剂 , 01
琼脂 13.5
pH(25℃) 7.1±0.2
配置
在495ml蒸馏水中溶解25.06克,加热至沸腾以完全溶解。15磅灭菌(121°C)15分钟。冷却到45°C。混匀,倒入无菌培养皿。
如果需要添加液态碲酸盐头孢克肟添加剂(FD147),在无菌培养基冷却前添加。
质量控制
● 外观——浅黄色至粉红色,单一自由流动粉末
● 成胶性——牢固,可与1.35%琼脂凝胶相媲美
● 制备好的培养基的颜色和透明度——在培养皿中为紫红色、澄清并稍不 透明的凝胶形式
● 配比浓度——5.01%w/v(5.01g/100ml水)水溶液在25°C下pH为7.1±0.2
● pH值——6.90-7.30
培养结果
5-37°C孵育18-24小时后观察培养特征(如有必要,可延至48小时)。
参考文献
1.Hansen W. and Yourassawsky E., (1984), J. Clin. Microbiol., 20:1177.
2.Karmali M.A., Petric M., Lim C., et al, (1985), J. Infect. Dis., 151-775.
3.Thompson et al. (1990). J. Clin. Microbiol. 29, 2165-2168.
4.Zadik P.M., Chapman P.A. and Siddons C.A., (1993), J. Med. Microbiol., 39, 155-158.
产品引用文献
1. Sreepriya Prakasan, Parmanand Prabhakar, Manjusha Lekshmi, Sanath Kumar,Binaya Bhusan Nayak.Isolation of Shiga toxin-producing Escherichia coli harboring variant Shiga toxin genes from seafood.Vet World. 2018 Mar; 11(3): 379–385.
2. SK Manna, C Manna,et al.Serogroup distribution and virulence characteristics of sorbitol-negative Escherichia coli from food and cattle stool.Journal of Applied Microbiology, 2010, 108 (2) :658–665
3. KM Mbae,MK Ndwiga,FG Kiruki.Microbiological Quality of Kachumbari , a Raw Vegetable Salad Popularly Served Alongside Roast Meat in Kenya.Journal of Food Quality,2018,(35):1-7

![[酶联免疫试剂盒] 其它ELISA试剂盒 <em>大肠杆菌</em>宿主残留蛋白(E.coli P)ELISA试剂盒](https://item.yiqi.com/pic/CovPic/1/2009103104451498.jpg)
![[免疫学试剂] 一抗 抗原抗体 Anti-EPEC/E.coli抗肠致病性<em>大肠杆菌</em>抗体](https://item.yiqi.com/pic/CovPic/1/201089105954389.jpg)
